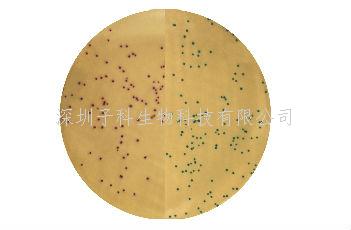
改良 MRSA 顯色培養(yǎng)基

熱門(mén)關(guān)鍵詞: ELISA試劑盒 - 大鼠ELISA試劑盒- 小鼠ELISA試劑盒
全國(guó)統(tǒng)一客服熱線:
0755-28715175
熱門(mén)關(guān)鍵詞: ELISA試劑盒 - 大鼠ELISA試劑盒- 小鼠ELISA試劑盒
全國(guó)統(tǒng)一客服熱線:
0755-28715175

結(jié)果:
微生物(Microorganisms) | 生長(zhǎng)情況 | 特征反應(yīng) |
表皮葡萄球菌ATCC?35984 | 生長(zhǎng)良好 | 藍(lán)綠色 |
金黃色葡萄球ATCC?43300 | 生長(zhǎng)良好 | 洋紅色 |
其他微生物 | 抑制 |
|
0755-28715175/33164177

粵公網(wǎng)安備 44030902000304號(hào)